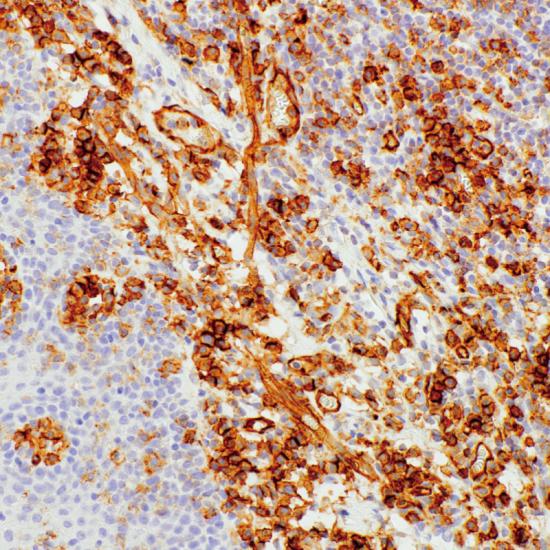

CD31 Antibody (Immunohistochemistry)
The CD31 Antibody, also known as PECAM-1 (Platelet Endothelial Cell Adhesion Molecule-1) or EndoCAM, is a major immunohistochemical marker for identifying endothelial cells and studying angiogenesis.
CD31 is a 130–140 kDa glycoprotein belonging to the immunoglobulin superfamily, expressed on endothelial cells, platelets, monocytes/macrophages, dendritic cells, and subsets of T and B lymphocytes.
In IHC staining, CD31 shows brown membranous and cytoplasmic staining, making it an essential marker for detecting vascular tumors and blood vessel formation.
🔬 Features and Benefits CD31 Antibody
-
Highly specific marker for endothelial cells
-
Clear membranous/cytoplasmic brown staining pattern
-
Useful for diagnosing vascular tumors (Angiosarcoma, Hemangioma)
-
Compatible with FFPE tissue and DAB chromogen system
-
Excellent stability: 18-month shelf life at 2–8 °C
💡 Diagnostic Applications
-
Identification of endothelial and vascular neoplasms
-
Evaluation of angiogenesis in tumor tissues
-
Differentiation of Angiosarcoma from non-vascular neoplasms
-
Research on vascular biology and cardiovascular pathology
🌐 Fardad Azma Rad Co.
Fardad Azma Rad Co., the exclusive representative of Talent Biomedical in Iran, provides premium-quality immunohistochemistry antibodies, including CD31.
With a strong commitment to scientific excellence, diagnostic accuracy, and international quality standards, the company supports pathology and molecular diagnostic laboratories across Iran.
There are no reviews yet.